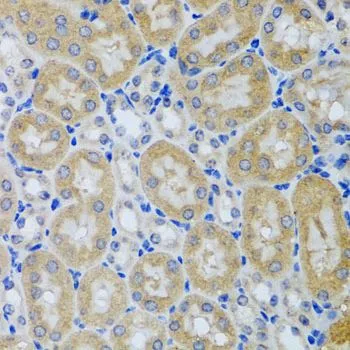
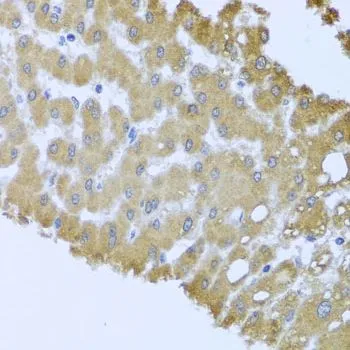

IHC-P analysis of human stomach tissue using GTX64697 ACP1 antibody. Dilution : 1:100
ACP1 antibody
GTX64697
ApplicationsWestern Blot, ImmunoHistoChemistry, ImmunoHistoChemistry Paraffin
Product group Antibodies
ReactivityHuman, Mouse
TargetACP1
Overview
- SupplierGeneTex
- Product NameACP1 antibody
- Delivery Days Customer9
- Application Supplier NoteWB: 1:500 - 1:2000. IHC-P: 1:50 - 1:100. *Optimal dilutions/concentrations should be determined by the researcher.Not tested in other applications.
- ApplicationsWestern Blot, ImmunoHistoChemistry, ImmunoHistoChemistry Paraffin
- CertificationResearch Use Only
- ClonalityPolyclonal
- ConjugateUnconjugated
- Gene ID52
- Target nameACP1
- Target descriptionacid phosphatase 1
- Target synonymsHAAP, LMW-PTP, LMWPTP, low molecular weight phosphotyrosine protein phosphatase, LMW-PTPase, acid phosphatase 1, soluble, acid phosphatase of erythrocyte, adipocyte acid phosphatase, cytoplasmic phosphotyrosyl protein phosphatase, low molecular weight cytosolic acid phosphatase, protein tyrosine phosphatase, red cell acid phosphatase 1, testicular secretory protein Li 37
- HostRabbit
- IsotypeIgG
- Protein IDP24666
- Protein NameLow molecular weight phosphotyrosine protein phosphatase
- Scientific DescriptionThe product of this gene belongs to the phosphotyrosine protein phosphatase family of proteins. It functions as an acid phosphatase and a protein tyrosine phosphatase by hydrolyzing protein tyrosine phosphate to protein tyrosine and orthophosphate. This enzyme also hydrolyzes orthophosphoric monoesters to alcohol and orthophosphate. This gene is genetically polymorphic, and three common alleles segregating at the corresponding locus give rise to six phenotypes. Each allele appears to encode at least two electrophoretically different isozymes, Bf and Bs, which are produced in allele-specific ratios. Multiple alternatively spliced transcript variants encoding distinct isoforms have been identified for this gene. [provided by RefSeq, Aug 2008]
- ReactivityHuman, Mouse
- Storage Instruction-20°C or -80°C,2°C to 8°C
- UNSPSC41116161